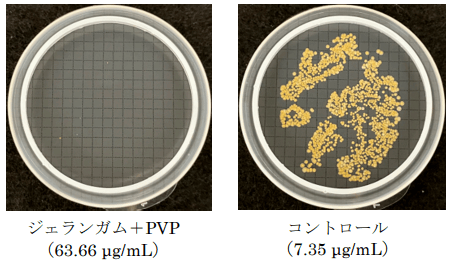

【新発見】 涙で流されにくく、べたつきを抑えた抗菌点眼剤技術
涙のミネラルと反応する、従来よりも高い滞留性のウォータージェル技術
大正製薬株式会社[本社:東京都豊島区 社長:上原 茂](以下、当社)は、“涙”のミネラル成分と反応するジェランガムと特定の粘稠剤の組み合わせにより、従来技術よりも高い滞留性のウォータージェルを形成することで、成分がより長く留まる新たな抗菌点眼剤技術を発見しました。
本技術により、1回点眼あたりの効果の持続が期待でき、アイメイクをしている日中や運転中手を離せない状況など、点眼剤の利用が制限されるシーンでの利便性が向上します。さらに、従来技術と比較して低粘度でべたつかないことから、使用感の向上も期待できます。


“涙”は涙腺から常に分泌され、目の表面をうるおす役割を果たしています。一般的に、点眼剤は“涙”により排出され、目に留まる時間は数分程度と言われています。しかし、細菌・花粉などの外的刺激や乾燥から目を長時間守るためには、点眼剤を角膜表面でより長く滞留させる必要があります。従来の滞留技術は、製剤粘度を上げる方法が一般的でしたが、目の周りに付着した粘性のある製剤によりべたつきを感じるという課題がありました。そこで当社は“涙”の中のミネラル成分と反応する性質を持つ「ジェランガム」と特定の粘稠剤※を組み合わせることに着目し、べたつきを抑えつつ、成分をより長く留まらせる新技術を見出しました。※ポリビニルピロリドン(PVP)
今回、当社の点眼研究において、確認したことは以下の3点です。
① 高い滞留性を実現する最適な成分の組み合わせを発見(特許出願中)
② 抗菌成分がより長く滞留することを確認
③ 滞留した抗菌成分が菌の増殖を抑制することを確認
以上の結果より、抗菌成分をはじめとする有効成分をより長く目の表面に留まらせることが可能となり、1回の点眼で効果が持続します。従来の粘性のある滞留型製剤と比べてべたつかないことから、使用感を向上させた点眼剤の開発が期待できます。
当社はこれからも点眼剤に関する様々な課題解決に向けて研究を進め、生活者の豊かな暮らしに貢献してまいります。
【研究内容①】
■高い滞留性を実現する最適な成分の組み合わせを発見
“涙”と反応した際の物理的な滞留性を液だれ試験にて評価しました。メンブランフィルターの上に人工涙液25 µLを滴下し、その上から点眼1滴量(50 µL)の製剤を乗せ、傾けた際の液だれを比較しました。その結果、ジェランガム・PVPの組み合わせは、ジェランガム・PVP非配合品(コントロール)に対し、高い滞留性を示しました(図2)。
さらに、この検討とは別に、種々の粘稠剤との組み合わせを検討した結果、ジェランガム・PVPの組み合わせは、液だれが最も抑制されることを確認しました(特許出願中)。
また、本技術を採用した製剤は、従来の粘度滞留型製剤(当社品)と比較して、べたつきの原因となる粘度を約41%に抑えることに成功しました。

【研究内容②】
■抗菌成分がより長く滞留することを確認
次に、本技術を採用した点眼剤における抗菌成分(スルファメトキサゾール)の滞留性を評価しました。スライドガラスに点眼1滴量(50 µL)の製剤を滴下し、6時間相当量の人工涙液で洗い流した後の抗菌成分の残存量を評価しました。
その結果、ジェランガム・PVP非配合品(コントロール)と比較して、ジェランガム・PVP配合品では、有意に多くの抗菌成分が残存することを確認しました。

【研究内容③】
滞留した抗菌成分が菌の増殖を抑制することを確認
さらに、研究内容②で残存することが確認された抗菌成分の濃度で、その抗菌力を評価しました。
その結果、ジェランガム・PVP非配合品では菌(黄色ブドウ球菌)の増殖が確認されたのに対し、ジェランガム・PVP配合品では菌の増殖は認められませんでした。このように、本技術によって、抗菌成分がより長く滞留し、菌の増殖を抑制することを確認しました。

【まとめ】
以上の結果より、抗菌成分をはじめとする有効成分をより長く目の表面に留まらせ、少ない点眼回数で効果の持続が可能となります。また、従来の粘性のある滞留型製剤と比べてべたつかない配合により、使用感を向上させた点眼剤の開発が期待できます。
当社は点眼剤に関わるあらゆる課題を解決するため、本研究をはじめとした様々な研究を進め、生活者のより豊かな暮らしの実現に貢献してまいります。